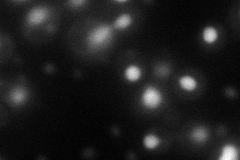
YIR009W
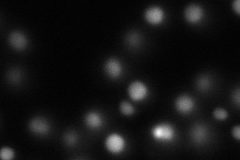
YIR009W
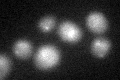
YIR009W

View description
U2B component of U2 snRNP, involved in splicing, binds the U2 snRNA stem-loop IV in vitro but requires association of Lea1p for in vivo binding; does not contain the conserved C-terminal RNA binding domain found in other family members
Localization:
Intensity:
Fold change:
Significance:
-
C’ GFP library in SD

nucleus:cytosol16.49 -
N' NOP1pr-GFP in SD
nucleus76.2992 -
N' TEF2pr-mCherry in SD
nucleus52.7708 -
N' NATIVEpr-GFP in SD

cytosol31.1106 -
N' TEF2pr-VC and Cyto-VN in SD

nucleus30.3917 -
C’ GFP library in SD+DTT
nucleus.cytosol17.281.04No -
C’ GFP library in SD+H2O2

nucleus.cytosol17.161.04No -
C’ GFP library in Starvation Media

nucleus,cytosol17.341.05No -
C’ GFP library on the background of Pup2-DaMP

nucleus:cytosol -
C’ GFP library on the background of CCT mutant

nucleus:cytosol15.4490.936377No
